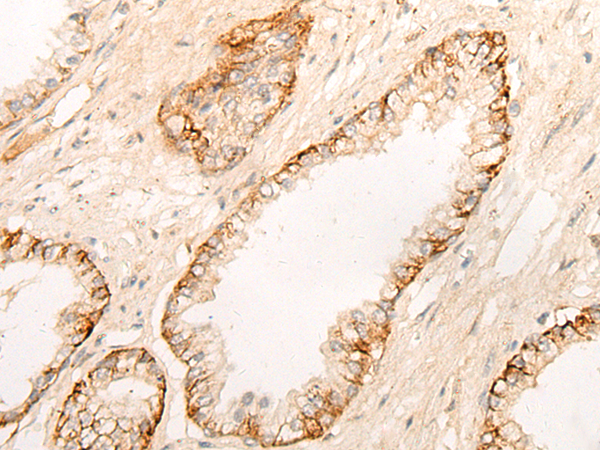

|
Background: |
This gene encodes a protein that is a member of the S9B family in clan SC of the serine proteases. The protein has been shown to have post-proline dipeptidyl aminopeptidase activity, cleaving Xaa-Pro dipeptides from the N-termini of proteins. Although the activity of this protein is similar to that of dipeptidyl peptidase 4 (DPP4), it does not appear to be membrane bound. In general, dipeptidyl peptidases appear to be involved in the regulation of the activity of their substrates and have been linked to a variety of diseases including type 2 diabetes, obesity and cancer. Several transcript variants of this gene have been described but not fully characterized. |
|
Applications: |
ELISA, IHC |
|
Name of antibody: |
DPP9 |
|
Immunogen: |
Synthetic peptide of human DPP9 |
|
Full name: |
dipeptidyl peptidase 9 |
|
Synonyms: |
DP9; DPLP9; DPRP2; DPRP-2 |
|
SwissProt: |
Q86TI2 |
|
ELISA Recommended dilution: |
5000-10000 |
|
IHC positive control: |
Human prostate cancer;Human lung cancer |
|
IHC Recommend dilution: |
20-100 |

購物車
購物車 幫助
幫助
 021-54845833/15800441009
021-54845833/15800441009
